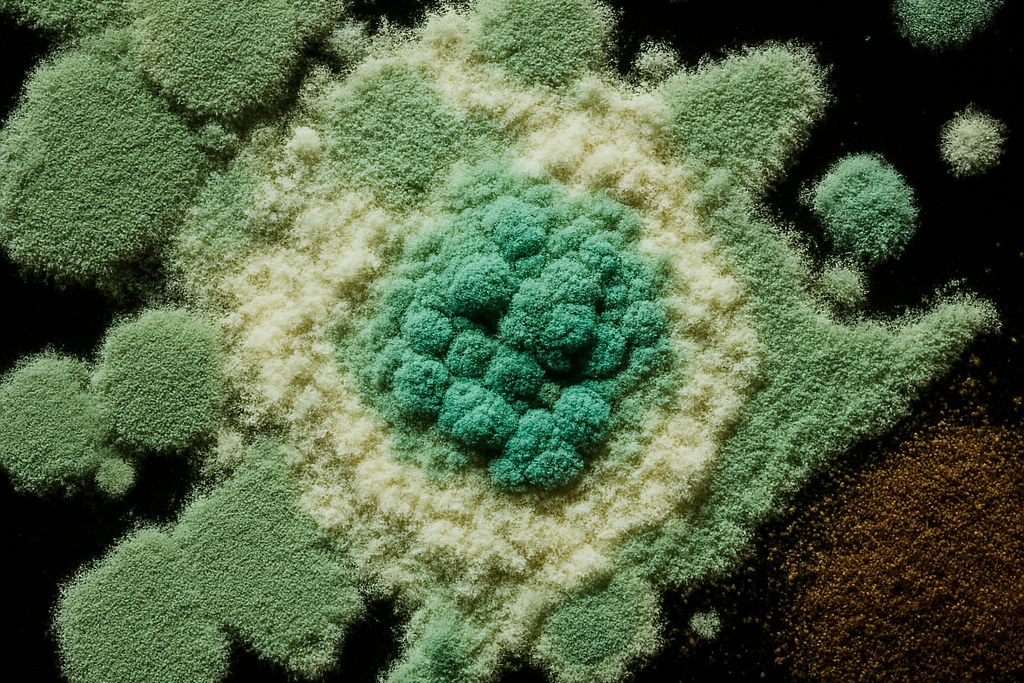
Microscopic picture of mold

Overview
At EBRC, our expertise is structured into five core fields, each of them built on many years of specialized experience. This structure ensures that the evaluation of substances is never carried out in isolation, but always considered within the context of different regulatory frameworks.
Behind every project, highly qualified scientists contribute their specialized knowledge in cross-disciplinary areas, while the communication with clients remains streamlined: a dedicated contact person takes responsibility for the project within its regulatory domain. This approach guarantees that clients have a single, reliable counterpart who maintains an overview of the project, while still benefitting from the depth and breadth of EBRC’s scientific expertise.
The five core fields cover the full spectrum of chemical safety and regulation, enabling EBRC to provide a comprehensive and integrated perspective that supports both industry and authorities. Please find below a more detailed description of EBRC’s involvement in each of these areas of expertise.
 Industrial Chemicals
Industrial Chemicals
REACH Registrations
With our services we support our clients from across the chemicals industry in fulfilling their obligations under Regulation (EC) No 1907/2006, known as the REACH Regulation, since its entry into force in 2007. Countless EBRC clients have successfully completed their REACH registrations at the key regulatory deadlines in 2010, 2013 and 2018. While these key milestones for registration of previously existing substances have passed, REACH is far from being over! New players on the market or newly developed chemicals still require new registrations. Compliance checks and dossier evaluations by the European Chemicals Agency (ECHA) continue. Registration dossiers need to be updated proactively, e.g. when new knowledge about the hazards and risk of chemicals emerges, or when new requirements are included in legislation.
We were actively involved in the compilation of complete registration dossiers either for individual companies or industry consortia for often multiple inorganic substances based on the following elements: Antimony (Sb), Arsenic (As), Barium (Ba), Boron (B), Bismuth (Bi), Cadmium (Cd), Calcium (Ca), Chrome (Cr), Cobalt (Co), Iron (Fe), Lead (Pb), Magnesium (Mg), Mercury (Hg), Molybdenum (Mo), Phosphorus (P), Selenium (Se), Silver (Ag), Strontium (Sr), Tellurium (Te), Titanium (Ti), Vanadium (V) and Zinc (Zn). Other consortia that have and still are entrusting EBRC with REACH-related tasks are covering sulfur-based chemicals (e.g. sulfur dioxide, sulfites and thiosulfates), inorganic pigments, gypsum, slags (ferrous and others), halogens (F, Br, I) and metal salts of fatty acids.
Previous experience under various stages of existing chemicals legislation in Europe encompass regulatory consulting, risk assessment and dossier compilation among others for important groups of chemicals such as flame retardants, organic solvents, surfactants/detergents, dyes/inks and plastic additives (phthalates).
Classification, Labelling and Packaging (CLP)
Closely interlinked with REACH is Regulation (EC) No 1272/2008 on classification, labelling and packaging of substances and mixtures (CLP). Founded in 1993, EBRCs experience with hazard classification has its foundation in early work for the chemical industry under the preceding EU Directives 67/548/EEC and 1999/45/EC on classification of dangerous substances and mixtures, and their respective national implementations. In relation to CLP, we support clients in self-classification of substances and mixtures and provide regulatory and scientific support in the context of harmonised classification. We have reviewed and commented upon proposals for harmonised classification several times.
History
Experience with regulations for new and existing chemicals has been gained at EBRC in more than three decades, starting with the involvement of now senior staff members in contract research from the 1980s. As full-time consultants since 1993, we supported major metal industries in risk assessments under the so-called Existing Substances Regulation (ESR, Council Regulation (EEC) No 793/93) and under Germany's own review program on existing chemicals.
In the period 1996-2003, EBRC was appointed as principal industry co-ordinator with overall responsibility for the human health section of the EU Risk Assessment Report (RAR) on Zinc and Zinc compounds. EBRC also has provided substantial support to the Nickel and Antimony industry in their EU ESR risk assessments and was involved in responsible functions for the Voluntary Risk Assessments on Lead and Lead compounds, and Copper and Copper compounds.
As early as the late 1980s, Germany embarked on its own existing chemicals review programme, setting up their "BUA" system. In this context, EBRC was involved in the compilation of over 60 complete IUCLID data sets, including running the complete profile of extensive literature searches, acquiring and evaluating primary literature, and entering and validating the data in IUCLID format. In addition, several of these compounds were selected for detailed review, for which EBRC staff acted as principal authors.

 Agrochemicals
Agrochemicals

Active Substances & Product Dossiers
- Very first active substance on Annex I covered by EBRC
- Broad spectrum of active substances covered (herbicides, fungicides, insecticides, rodenticides)
- More than 25 complete notification dossiers for PPP a.s. submitted
- All substances submitted under Dir 91/414 existing substances review and Reg 1107/2009 have successfully been EU approved so far
- More than 100 product registration dossiers for national registrations submitted (zonal dossiers)
- IUCLID: EBRC was involved in the first round of PPP IUCLID submissions and has more than 25 years of experience with IUCLID submissions for Industrial Chemicals
- EBRC was involved in first round of PPP IUCLID submissions
EBRCs Background in Registration of Active Substances and Plant Protection Products
With almost thirty years of regulatory expertise, EBRC has built a strong track record in supporting the registration of active substances and plant protection products (PPPs) within the European Union.
Experience with Active Substances
EBRC was part of the EU registration system from the very beginning – the very first active substance listed on Annex I was successfully covered by our consultancy. Over the years, EBRC has worked with a broad spectrum of active substances, including herbicides, fungicides, insecticides, and rodenticides. To date, we have prepared and submitted more than 25 complete notification dossiers for active substances. All dossiers submitted under both Directive 91/414/EEC and Regulation (EC) No 1107/2009 have successfully achieved EU approval.
Comprehensive Expertise in Product Registrations
EBRC has been working with IUCLID for more than 25 years for the registration of Industrial Chemicals, providing unparalleled expertise in electronic dossier preparation and submission. This experience easily translates into the agrochemicals department. We were actively involved in the very first round of PPP IUCLID submissions, contributing to the development and practical implementation of digital dossier systems in the EU regulatory process.
Our Commitment
Through our scientific expertise, regulatory insight, and consistent record of successful submissions, we have become a trusted partner for companies seeking efficient and compliant registration of their active substances and products. Due to our experienced and flexible staff, we can react on challenging workloads and handle tight deadlines.
Comprehensive Regulatory Support for Active Substances and Plant Protection Products under Regulation (EC) No 1107/2009
As an experienced regulatory consultancy, we provide expert and tailored support throughout all key phases of the EU and national registration process for active substances and plant protection products.
EU Notification and Support of Active Substances
We assist in the notification, and renewal of active substances under Regulation (EC) No 1107/2009 – from dossier preparation to successful approval. Our services include:
- Support of existing active substances within the EU renewal (AIR) process
- Support of new active substances,
- Completeness checks and validation of existing studies
- Full dossier preparation, including comprehensive risk assessments
- Submission and expert support during the review and evaluation phases
Regulatory Support for Plant Protection Products
We offer professional guidance and hands-on support in all stages of national and EU registration of plant protection products (CP) according to Regulation (EC) No 1107/2009. Our expertise covers:
- Preparation of CP dossiers (dRR) for registration and re-registration at zonal or national level within EU Member States
- Label extensions, mutual recognition and formulation changes
- Compilation of all required documents and conduct of exposure and risk assessments
- Advice on data gap closure and supervision of experimental studies
- Submission to competent authorities, including electronic submission via CADDY/IUCLID
- Ongoing communication and follow-up with authorities throughout the registration process
 Biocides
Biocides
Registration under the Biocidal Products Regulation (EU) 528/2012 (BPR)
Since the implementation of the Biocidal Products Directive 98/8/EC and the subsequent BPR (EU Regulation No. 528/2012), EBRC has become a trusted partner for manufacturers, importers, and distributors of biocidal products in navigating the complex regulatory framework, from active substance approval to product authorisation. EBRC has been responsible for the notification and support of more than 35 biocidal active substances and a corresponding number of biocidal products – including the preparation, submission, and defence of comprehensive IUCLID dossiers and corresponding assessment reports.
EBRC supports companies in obtaining EU approval of active substances and in securing product authorisations at both national and Union level. With experience across nearly all 22 Product Types (PTs) listed in Annex V of the BPR – from disinfectants and preservatives to insecticides and rodenticides – EBRC offers broad technical and regulatory coverage.
Support in early active substance development
- Assisting with the compilation of regulatory data requirements
- Conducting data gap analysis, planning and monitoring studies , and evaluating literature
- Performing environmental, occupational and consumer risk assessments
Active substance authorisation or support
- Assessment of active substance regulatory status
- Compilation of IUCLID Dossier in line with the BPR Annexes
- Coordination with data holders and substance suppliers
- Application for Technical equivalence
Biocidal product authorisation
- Preparation of product authorisation dossiers
- Support in compiling family application procedures, union authorisations or mutual recognition processes
Our comprehensive scientific expertise and many years of experience in the field of regulatory requirements have resulted in the successful completion of all EU regulatory applications we have prepared to date.
 Food & Feed Additives
Food & Feed Additives

Food & Feed
In today’s evolving EU regulatory landscape, bringing food and feed additives to market requires a precise balance of scientific evidence and regulatory compliance. At EBRC, we deliver expert consulting services designed to help you meet all requirements under EU food and feed additive legislation and related EFSA guidance documents.
We are scientific and regulatory specialists with a strong focus on nanoform assessment and inorganic colourants, helping you anticipate regulatory expectations and demonstrate product safety with confidence.
Our Expertise Includes:
- Nanoform Assessment & Characterisation: Comprehensive evaluation of nanomaterials, including physicochemical characterisation, exposure assessment, and risk evaluation according to EFSA and ECHA guidelines.
- Inorganic Colourants & Pigments: Scientific support for metal oxide and other inorganic colour additives — from impurity and particle size analysis to toxicological data generation and dossier preparation.
-
Regulatory and Scientific Consulting:
- Food and feed additive dossier preparation for EFSA submission
- Safety and toxicological data gap analysis
- REACH–food law interface assessment for dual-use substances
- Liaison with regulatory authorities and scientific panels
 Cosmetics
Cosmetics
Cosmetics
Bringing innovation to market in the EU cosmetics sector requires more than science — it demands compliance, precision, and deep regulatory insight.
At EBRC, we specialize in scientific and regulatory consulting for complex cosmetic ingredients. Our experts guide you through the complex landscape of EU Cosmetics Regulation, ensuring your substances meet the highest standards of safety and compliance.
Whether you’re facing introducing a novel cosmetic ingredient or seeking toxicological assessments and safety evaluations, we provide the scientific rigor and regulatory expertise you need to succeed.
Our expertise includes:
- Nanoform Assessment & Characterisation: Full scientific and regulatory support for nano-scale materials, including physicochemical characterisation, safety evaluation, and dossier preparation in line with SCCS and REACH guidance.
- Inorganic Colourant Evaluation: Specialist knowledge in metal oxides and other inorganic pigments — from impurity profiling and particle size analysis to toxicological review and regulatory justification.
-
Comprehensive Regulatory Services:
- Compliance gap analysis and regulatory strategy
- Toxicological and safety assessment
- Liaison with authorities and regulatory monitoring
- Proven expertise in nanoform-specific regulatory compliance


